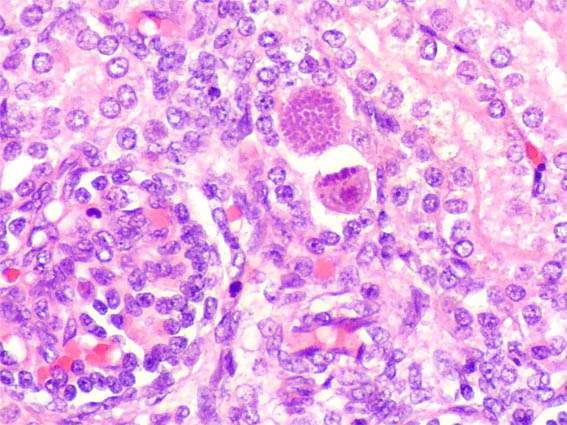
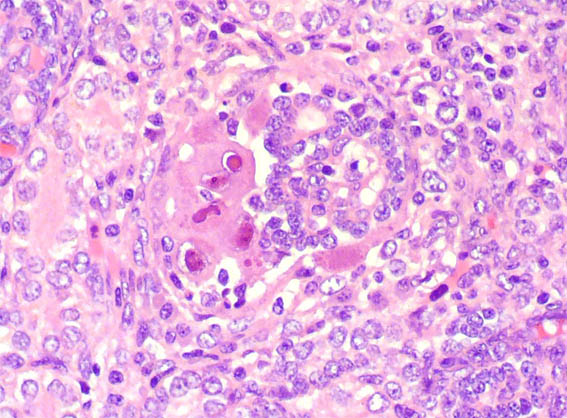

Caso
90 Con discusión |
English
version |
|||
CASO 90 (Agosto 2013)
Datos clínicos:
Una mujer de 21 años de edad, primigestante, presenta muerte fetal a las 23 semanas de gestación, sin alguna alteración previa aparente. Control prenatal normal. No hipertensión. No alteraciones en exámenes de sangre gestacionales. Hemoleucograma previo (un mes antes) normal. No síntomas sistémicos, no fiebre, no cefalea, nauseas o vómito.
Se induce el parto y se hace autopsia fetal.
En ambos riñones fetales se observa lo mostrado en las siguientes imágenes.

Figura 1. H&E, X100.

Figura 2. H&E, X400.

Figura 3. H&E, X400.

Figura 4. H&E, X400.
Figura 5. H&E, X400.

Figura 6. H&E, X400.

Figura 7. H&E, X400.
Figura 8. H&E, X400.

Figura 9. H&E, X400.

Figura 10. H&E, X400.
¿Cuál es su diagnóstico?